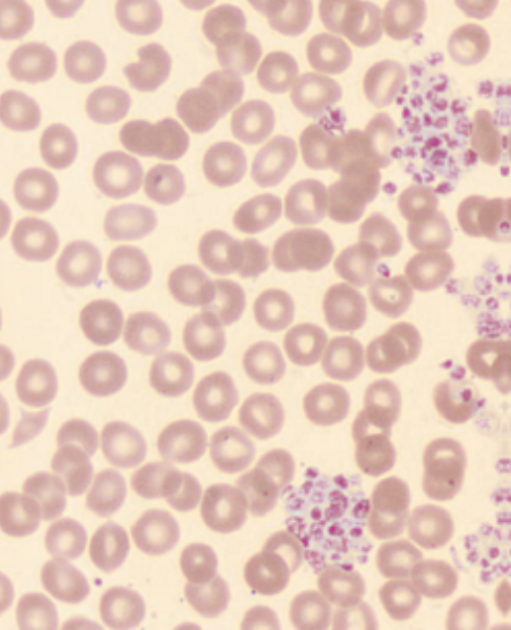

Praksisnytt
Trombocytter inkluderes i enkel hematologistatus
Fra 29. april vil enkel hematologistatus også inneholde trombocytter.
Dette skjer etter ønske fra leger ved SiV og fordi sentrallaboratoriet har fått tilbakemelding om at noen bestiller utvidet hematologistatus bare for å få med trombocytter (og ikke egentlig trenger differensialtelling av leukocytter).
Trombocytter blir uansett analysert av våre hematologiinstrumenter, mens en differensialtelling krever en ekstra omkjøring med dyre reagenser og genererer ofte merarbeid med vurdering av celleplot og eventuell blodutstryk.
- Enkel hematologistatus: hemoglobin, erytrocytter, MCH, og leukocytter - og nå også trombocytter
- Utvidet hematologistatus: hemoglobin, erytrocytter, MCV, MCH, MCHC, trombocytter og leukocytter med differensialtelling i fem celleklasser
Dersom du av en eller annen grunn ikke ønsker svar på trombocytter, er det mulig å slette trombocytter fra bestilte analyser i DIPS Interactor:

Trombocyttaggregater kan gi falskt lavt trombocyttall. Ved trombocytopeni (< 100 ⋅ 109/L) som ikke er kjent fra før på pasienter fra primærhelsetjenesten, vil laboratoriet utføre mikroskopi av blodutstryk og undersøke om det foreligger trombocyttaggregater.